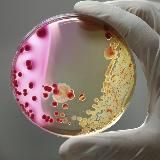
Микробиология - изучаем вместе

- Exchange
- Sandbox
- Deleted
- GIF and Video869
- IT835
- SMM7134
- Telegram8282
- Auto and moto6243
- Author's blog2916
- Gambling582
- Jokes152
- Anime798
- Poster224
- Business and Finance16642
- Bloggers32604
- Military256
- All sorts10420
- Horoscopes and Esoterica5983
- Darknet757
- Design5735
- For Adults2428
- For men600
- For Parents5848
- USE and Exams8947
- Health8744
- Games15929
- Instagram1919
- Art5977
- Catalog228
- Coronavirus233
- Красота и мода19039
- Cryptocurrencies15501
- Cooking8446
- Lifehacks200
- Linguistics3781
- Literature7381
- Stores and Sales16521
- Medicine6484
- Mobile1624
- Music16077
- Science and Technology10101
- Real Estate1726
- News39177
- Education14597
- Single-line146
- Podcasts155
- Heard200
- Educational1479
- Politics15295
- Porn24043
- Nature and Animals5793
- Predictions and Bets9678
- Proxy40
- Psychology13416
- Travel11162
- Mixed173021
- Regional1697
- Religion9868
- Crafts2228
- Services162
- Leaks606
- Software196
- Sports10339
- Stickers190
- Construction and renovation4900
- Remote Work7027
- FEM-BLM164
- Facts868
- Movies and Series11616
- Photo10823
- Freebies and Discounts1461
- Quotes8711
- Chats67649
- Shock Content1674
- Ecology117
- Economy9334
- Humor14304
- Law2807
- 🇦🇲 Armenian Channels203
- 🇦🇿 Azerbaijani channels206
- 🇧🇾 Belarusian channels992
- 🇬🇪 Georgian Channels47
- 🇰🇬 Kyrgyz channels608
- 🇰🇿 Kazakhstan channels713
- 🇲🇩 Moldovan channels48
- 🇹🇯 Tajik channels632
- 🇺🇦 Ukrainian channels16424
- 🇺🇿 Uzbek channels8953
Sandbox

0
Sometimes You Just Have To Shut The World Out, Close Your Eyes And Turn The Music Up... @husseinabbasnejad Friend channels: @PUNK_ALBUMS @PUNK_METAL @PUNK_FOR_EVER @unite_world_folklore @HXRRXR @World8Bit @WaveArt

0
89174421363 ватсап ПОВЕДЕНЧЕСКИЙ ФАКТОР (ПФ) на Авито Отзывы на авито Удаление негативных отзывов Ведение аккаунтов Накрутка Заказать услуги: @multimillionerz Наш чат: https://t.me/pf_avito_chat Авитолог Настройка авито под ключ Аккаунты верифицированные

0
ДЕЛАЙ ДЕНЬГИ ЗДЕСЬ И СЕЙЧАС! 🔥проект IGRA - возможность заработать без вложений. Слушай голосовые. 🔑 Ключ от ваших денег👇 Переходи по ссылке. https://triumff.it/sh/qqgZm Забирай свои деньги💰 Все официально. Платят банки России.

0
Всем здравствуйте!👋 Здесь мы будем делиться эффективными заработками в интернете и зарабатывать деньги💵

0
Я - ключ к твоей успешной жизни💯 Единственный канал с инвестициями ✅ По вопросам: @miste4e